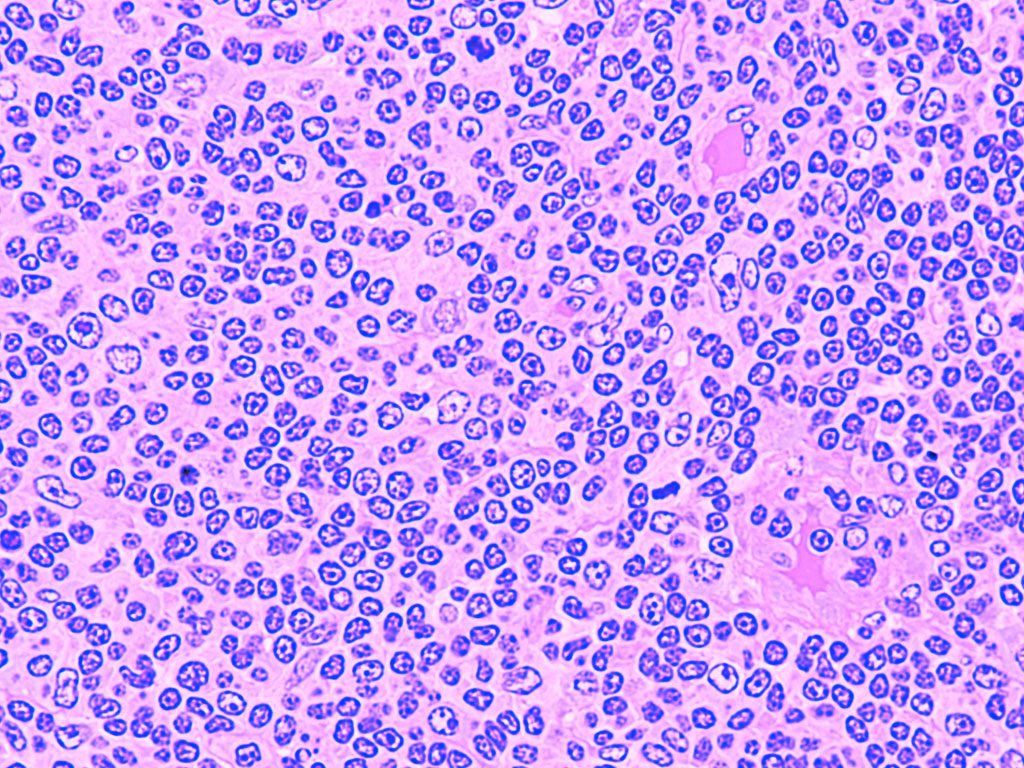

Известно, что иммунная система, как и другие системы организма, подчиняется циркадным ритмам — суточным колебаниям активности. Такой порядок необходим для ее корректной работы. Циркадной осцилляции, например, подвержены лейкоциты (нейтрофилы и монофилы): в зависимости от времени суток меняется интенсивность их миграции между кровью и тканями. При этом одна из групп лейкоцитов — лимфоциты — курсирует между кровью и лимфоузлами, где они временно удерживаются с помощью адренергической нервной системы. Последняя напрямую поддерживает активность таких органов, как сердце, легкие и кишечник, но с учетом последних данных, она может быть связана и с лимфоидными органами — тимусом и костным мозгом. Однако механизм курсирования лимфоцитов и его связь с адренергической нервной системы до сих пор не изучены.
Ученые из Осакского университета предположили, что в основе перемещения лимфоцитов также лежат циркадные колебания. Для проверки гипотезы они измерили уровень лимфоцитов (B- и Т-клеток) в крови, лимфе и периферических лимфатических узлах мышей в разное время суток. Результаты показали, что спустя пять часов после включения источника освещения содержание лимфоцитов в крови животных достигло максимума, как и в лимфе, — ранее о суточных колебаниях этих клеток в лимфе было неизвестно. Дна показатель достиг через 17 часов после включения света (в темное время суток), при этом одновременно число лимфоцитов резко выросло в лимфатических узлах.
Затем авторы проанализировали связь лимфоцитов с адренергической нервной системой. Для этого животных разделили на три группы. Одним мышам ввели нейротоксин 6-гидроксидофамин (также используется для моделирования нейродегенеративных заболеваний, например болезни Паркинсона), что ослабило общую адренергическую нейромедиацию в их мозге. У других особей ученые «выключили» только ?2-адренорецепторы, которые расположены на B- и T-клетках и, предположительно, «отвечают» за удержание лимфоцитов в лимфатических узлах. Третья группа была контрольной.
Последующий анализ показал, что в первой группе мышей сокращение лимфоцитов в крови и лимфе в темное время суток было менее выраженным по сравнению со здоровыми особями. Аккумуляции лимфоцитов в лимфатических узлах при этом также не произошло. Вместе с тем у животных с дефектным ?2-адренорецептором наблюдалась тенденция к увеличению лимфоцитов в крови и лимфе в дневное время суток. Авторы считают, что это может быть связано с действием другого ?2-агониста — адреналина: он частично компенсировал дефект. Кроме того, в компенсации могли участвовать ?3-адренорецепторы.
На третьем этапе эксперимента ученые заблокировали доступ лимфоцитов в лимфатические узлы путем обработки антител против интегрина альфа-4 и интегрина альфа-L (мембранные белки на T- и B-клетках). Блокировка осуществлялась спустя час или 13 часов после включения источника освещения и в обоих случаях длилась 12 часов. Согласно полученным данным, при блокировке доступа через 13 часов количество лимфоцитов в лимфатических узлах животных оказалось выше, чем при блокировке через час. Это указывает на ограничение возможности для выхода клеток из лимфоузлов в темное время суток.
По мнению авторов, накопление лимфоцитов в лимфоузлах в темное время суток может быть адаптивным механизмом: мыши ведут ночной образ жизни, и имеют повышенный шанс столкнуться с патогеном в это время. На клеточном уровне аккумуляция позволяет B- и T-клеткам эффективнее изучить профиль проникающих в организм патогенов и, как следствие, лучше бороться с ними после выхода в кровь и лимфу. У человека накопление лимфоцитов в лимфоузлах происходит, напротив, в дневное время суток, когда адренергическая нервная система наиболее активна.